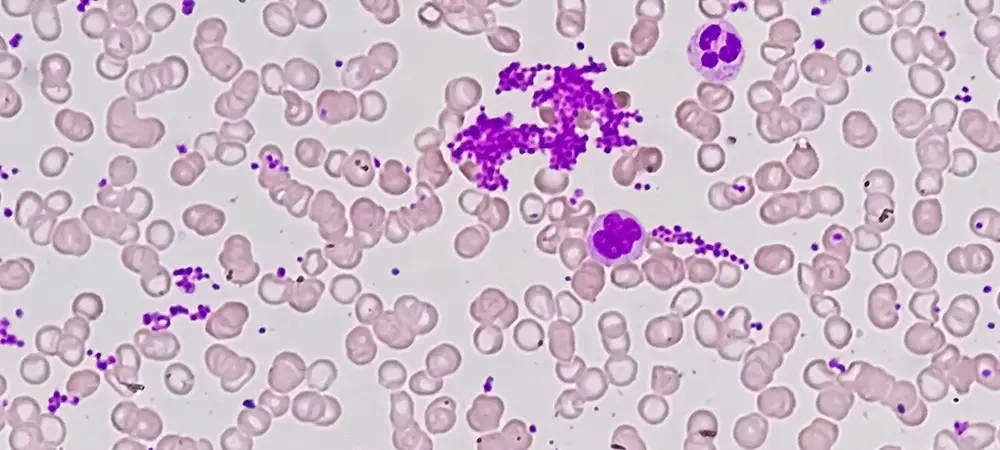
entry image

Trombosit (PLT) nedir? Trombosit yüksek olması ne demek?
Trombositler, kanda dolaşan küçük, yuvarlak hücre parçalarıdır. Kan pıhtılarının oluşumu için gereklidirler, vücudun kanamayı durdurmak için oluşturduğu kan kütleleridir. Trombosit sayısı testi (PLT), kanınızda bulunan trombosit sayısını ölçen bir laboratuvar testidir. Bu test, trombosit seviyelerinin çok düşük veya çok yüksek olduğunu tespit edebilir. Düşük trombosit seviyeleri, vücudun kan pıhtıları oluşturmasını zorlaştırır ve bu da aşırı kanamaya neden olabilir. Yüksek trombosit seviyeleri çok fazla pıhtılaşmaya neden olabilir. Kan damarlarındaki kan pıhtıları akciğerlerde, bağırsaklarda, beyinde veya kalpte yerleşebilir ve bu da ciddi tıbbi rahatsızlıklara neden olabilir.
- İçindekiler
- Trombosit (PLT) nedir?
- Trombosit (PLT) kaç olmalı?
- Kadınlarda PLT kaç olmalı?
- Trombosit (PLT) yüksekliği neden olur?
- Trombosit (PLT) yüksekliği belirtileri
- PLT yüksekliği hangi hastalıkların belirtisidir?
- Trombosit (PLT) yüksekliği tedavisi
- PLT düşüklüğü neden olur?
- Trombosit (PLT) düşüklüğü belirtileri
- Trombosit yüksekliği kanser belirtisi midir?
Trombosit (PLT) nedir?
Trombositler kanınızın pıhtılaşmasına yardımcı olur. Trombosit sayımı (PLT), kanınızdaki trombosit sayısını ölçen bir testtir. Düşük trombosit, kanser, enfeksiyon veya diğer sağlık sorunlarının bir işareti olabilir. Çok yüksek trombosit sayısı ise, sizi kan pıhtısı veya felç riski altına sokabilir.
Trombosit (PLT) kaç olmalı?
Normal trombosit sayısı, bir mikrolitre kanda 150.000 ile 450.000 arasında değişir. 450.000'den fazla trombosite sahip olmak trombositoz adı verilen bir durumdur; 150.000'den az olması ise trombositopeni olarak bilinir.
Kadınlarda PLT kaç olmalı?
Normal trombosit sayısı, mikrolitre kan başına 150.000 ila 450.000 arasındadır. Kadınlar için ortalama trombosit sayısı, mikrolitre kan başına 157.000 ila 371.000 arasındadır.
Trombosit (PLT) yüksekliği neden olur?
Yüksek trombosit sayısı (trombositoz): Mikrolitrede 450.000’den fazla trombosit bulunmasıdır. Trombosit sayısı çok yüksekse, kan damarlarında kan pıhtıları oluşabilir. Bu, vücuttaki kan akışını engelleyebilir. Trombositemi, başka bir sağlık durumundan kaynaklanmayan yüksek trombosit sayısını ifade eder. Bu duruma bazen birincil veya esansiyel trombositemi denir.
Çok fazla trombosit bulunmasının tıbbi terimi trombositozdur ve iki türü vardır:
Primer veya esansiyel trombositoz
Kemik iliğindeki anormal hücreler trombosit sayısında artışa neden olur, ancak nedeni bilinmemektedir.
Sekonder trombositoz
Primer trombositozla aynı durumdur, ancak anemi, kanser, iltihaplanma veya enfeksiyon gibi devam eden bir durum veya hastalıktan kaynaklanabilir.
Semptomlar olduğunda, tedavi edilmezse kalp krizi ve felce yol açabilen kollarda ve bacaklarda kendiliğinden oluşan kan pıhtıları da buna dahildir. Şiddetli vakalarda, hastanın trombosit aferezi adı verilen bir prosedüre girmesi gerekebilir. Bu, kanı alarak, trombositleri ayırarak ve kırmızı kan hücrelerini vücuda geri döndürerek trombosit sayısını düşürür.
Sekonder trombositozda, semptomlar genellikle ilişkili durumla ilişkilidir. Örneğin, bir enfeksiyonunuz veya aneminiz varsa, bu durumları tedavi edersiniz ve trombosit sayınız düşer.
Trombosit (PLT) yüksekliği belirtileri
Yüksek trombosit sayısının belirtileri çoğunlukla kan pıhtısından kaynaklanır. Belirtileriniz şunları içerebilir: Göğüs ağrısı ve kalp çarpıntısı, nefes almada zorluk, baş dönmesi, görüşünüzde değişiklikler, güçsüzlük, uyuşukluk, peltek konuşma veya geçici iskemik ataklar.
PLT yüksekliği hangi hastalıkların belirtisidir?
Trombosit (PLT) sayısının yüksek olması birçok nedene bağlıdır. Yaygın olarak, enfeksiyonlar ve kronik hastalıklar, düşük demir miktarı, belirli kanser türleri, böbrek, lenfoma ve lösemi PLT yüksekliği nedenleri arasındadır.
Trombosit (PLT) yüksekliği tedavisi
Eğer belirtileriniz yoksa sadece rutin kontrollere ihtiyacınız olabilir. Trombositozun sekonder formları nadiren tedavi gerektirir. Genellikle, yüksek trombositlere neden olan durum (yaralanma, enfeksiyon, cerrahi müdahaleye yanıt, vb.) düzeldikten sonra seviyeler normale döner. Semptomlarınız varsa, doktorunuz altta yatan nedeni tedavi edecektir. Trombosit yüksekliği durumunda kanın pıhtılaşmasını önlemek amacıyla kan sulandırıcı ilaçlar (antikoagülanlar) reçete edilebilir.
PLT düşüklüğü neden olur?
Düşük trombosit sayısı (trombositopeni): Mikrolitrede 150.000'den az trombosittir. Yeterli trombositiniz olmadığında buna trombositopeni denir. Semptomlar arasında kolay morarma ve diş etlerinden, burundan veya GI yolundan sık kanama bulunur. Vücudunuzun trombosit üretmesini engelleyen bir şey olduğunda trombosit sayınız düşer. Bunun çok çeşitli nedenleri vardır, bunlar şunlardır:
İlaçlar.
Kalıtsal bir durum.
Lösemi veya lenfoma gibi bazı kanser türleri.
Kanser için kemoterapi tedavisi.
Böbrek enfeksiyonu veya işlev bozukluğu.
Aşırı alkol.
Trombosit (PLT) düşüklüğü belirtileri
Trombositopeni semptomları genellikle trombosit sayısı çok düşük olana kadar gelişmez. Düşük trombosit sayısı semptomları kemoterapi başladıktan kısa bir süre sonra başlayabilir, ancak genellikle ilk kemoterapiyi aldıktan 10-14 gün sonra en kötü hallerine gelirler.
Trombosit sayısının düşük olmasının belirtileri şunlardır:
Kolayca morarma.
Cilt altında küçük kırmızı noktalar.
Diş etlerinde veya burunda alışılmadık kanama.
Küçük bir kesikten bile çok fazla veya uzun süreli kanama.
İdrarda pembe, kırmızı veya kahverengi görünebilen kan.
Dışkıda kan veya siyah renkli dışkı.
Kan veya kahve telvesine benzer şekilde kusmak.
Normal adet döneminden farklı olan ve daha uzun süren vajinal kanama.
Sürekli baş ağrısı, bulanık görme veya bilinç düzeyinde değişiklik.
Kemoterapiye bağlı trombositopeni genellikle geçicidir, ancak iç organlara zarar verebilecek ciddi kan kaybına veya kanamaya neden olabilir.
Trombosit yüksekliği kanser belirtisi midir?
Yaygın olarak yüksek trombosit sayısına akut kan kaybı, enfeksiyon ve iltihap gibi durumlar neden olur. Katı tümör kanserleri bazen trombosit sayısının o kadar yüksek olmasına yol açabilir ki, teşhis edilmemiş bir kanser genellikle trombositozlu bir hastanın tanısal çalışmasında dikkate alınır.





























